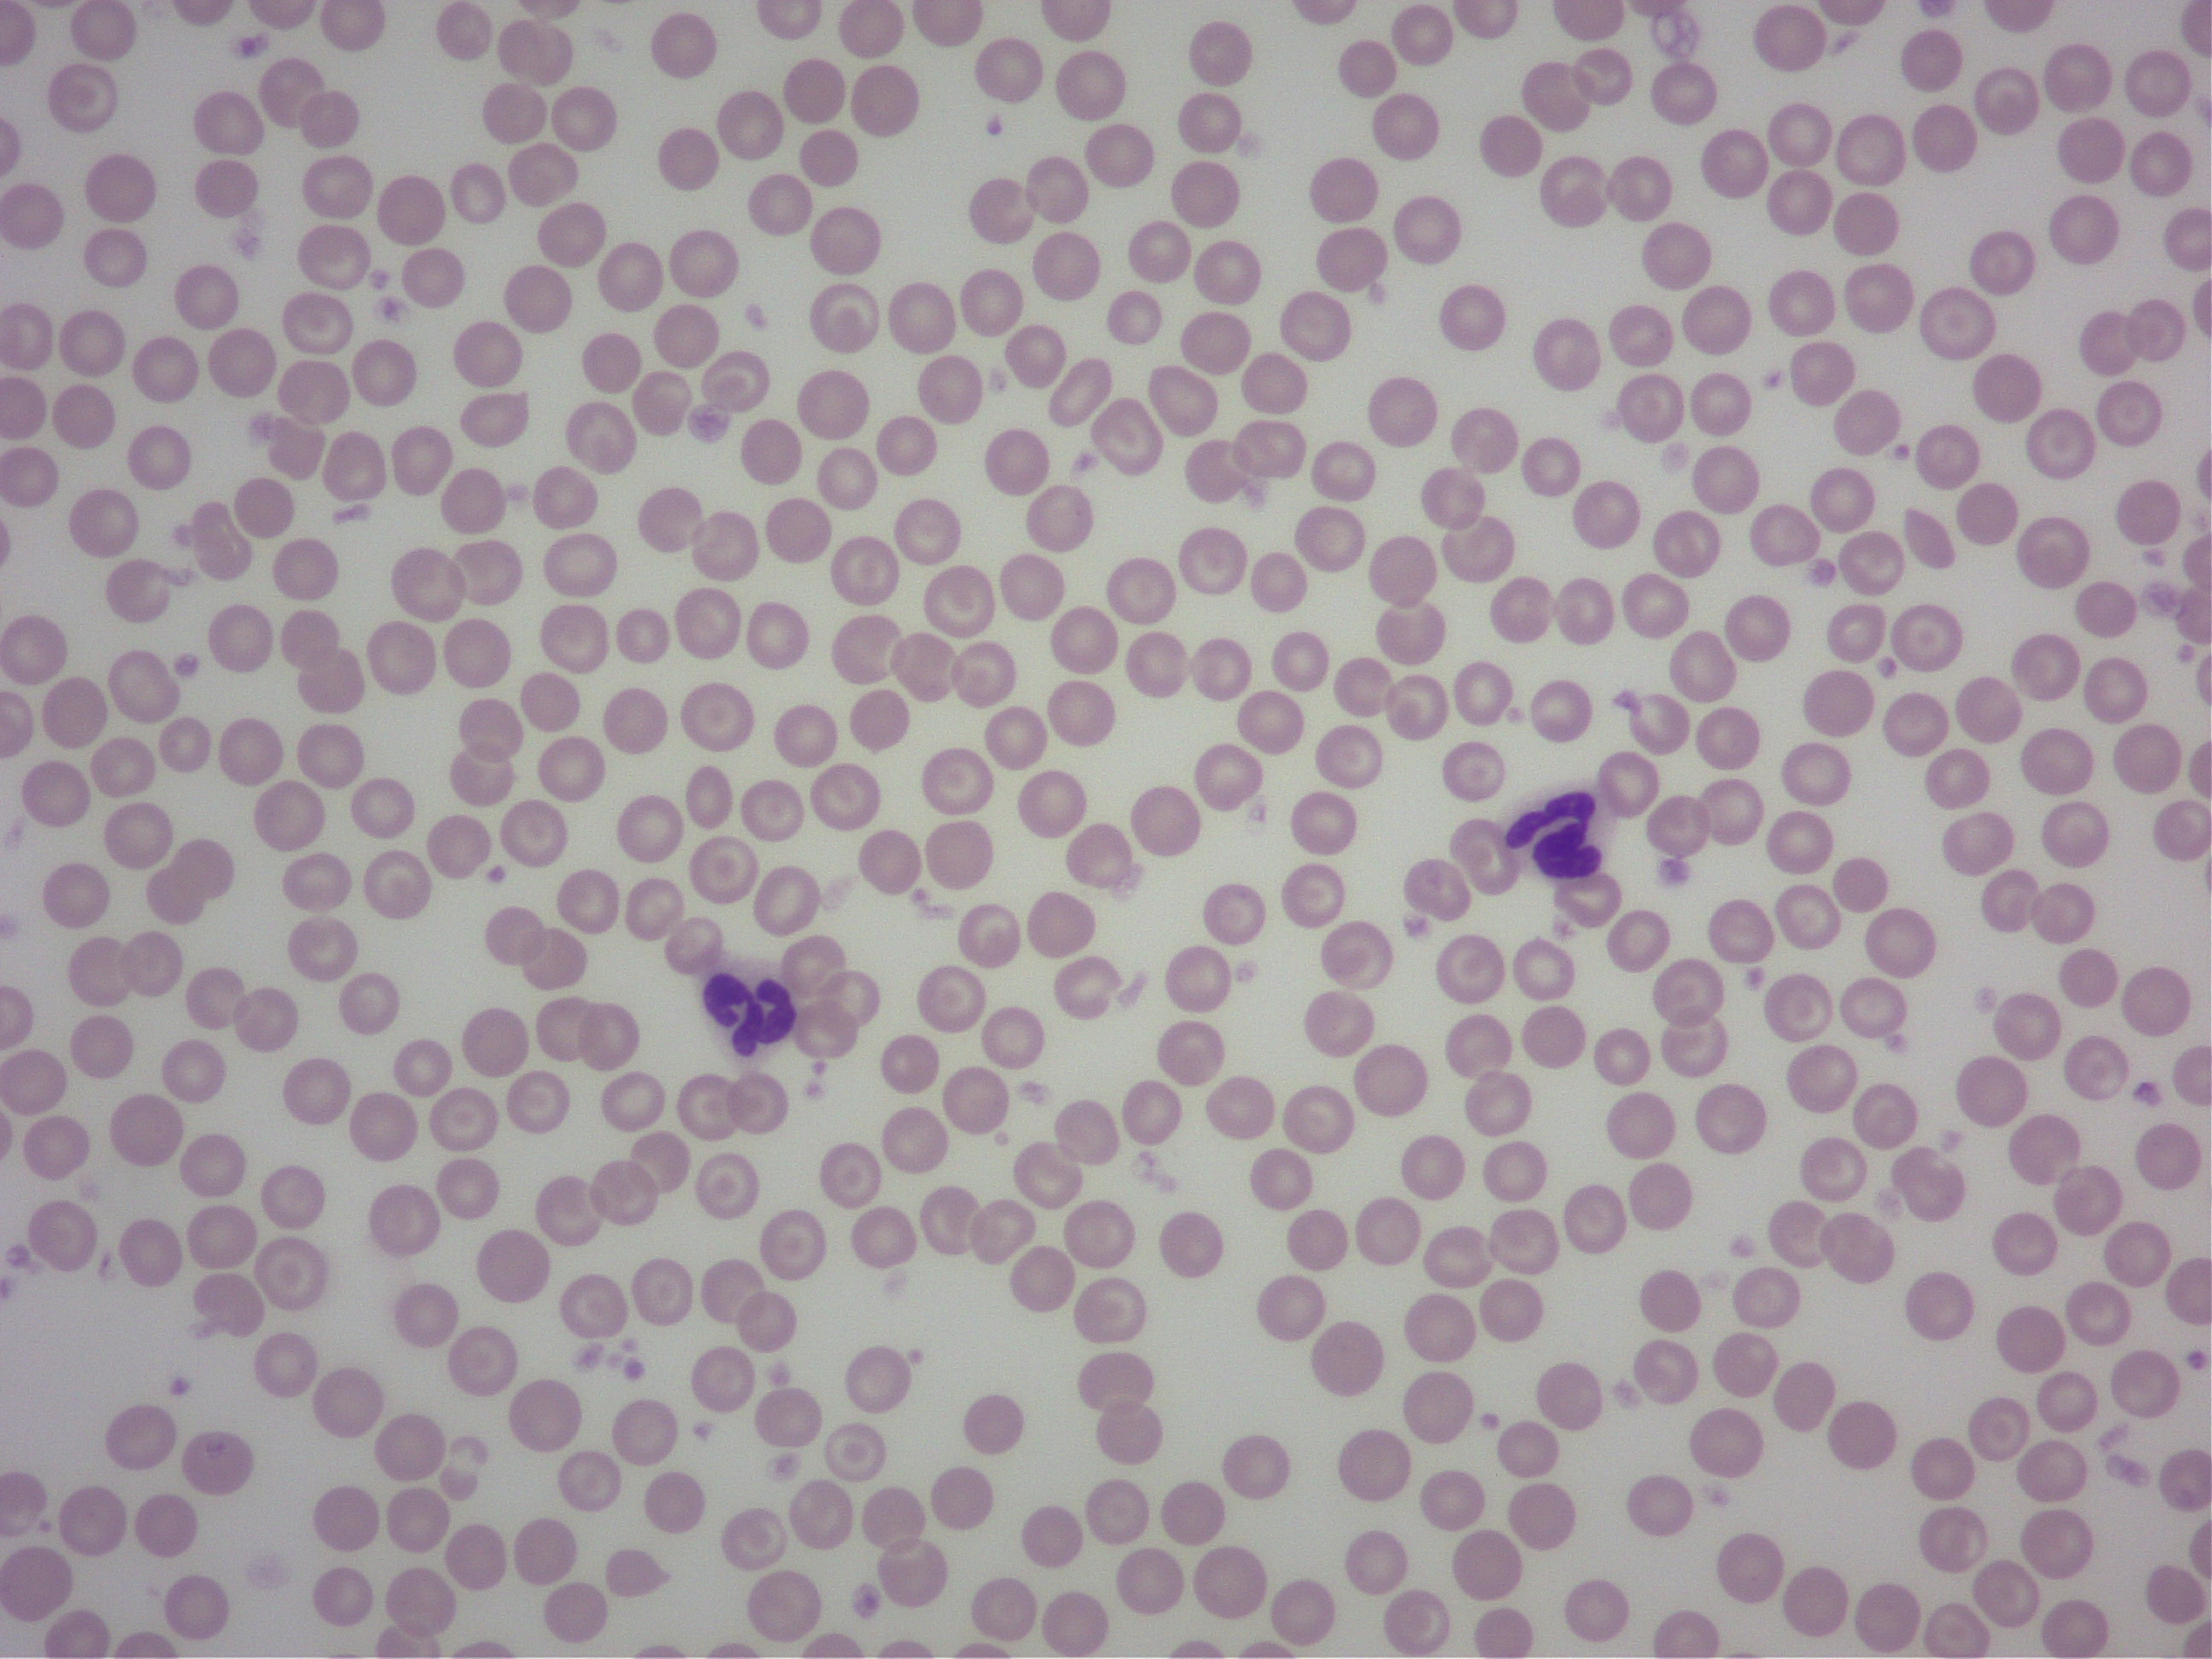
好中球の顕微鏡画像

みなさん、こんにちは。院長の諏訪です。
梅雨入りして、ジメジメした日が続きますね。
曇りばかりだと、なぜか気分も曇ってしまいがちです。
気持ちもそうですが、曇りがちな時ほど、この先に待ってる明るい未来を目指して、日々精進していきたいと思っています。
ちなみに僕の家の植物たちは、雨が降って喜んでいるようです。
今年は大葉、ねぎ、オクラ、きゅうりなどを育て始めました!
どんな風に育ってくれるのか楽しみです。

本日は論文の話はお休みにして、普段見ている血液のお話をさせていただきます。
僕は血液学にとても興味があり、開業する前は岡山県の山陽動物医療センターで勤務し、
院長である下田先生からとても多くのことを学びました。
血液学のことはもちろんですが、獣医師として、人として、どう生きるべきか、
どのような獣医師となるべきか。今もいつも自分に言い聞かせています。
さて、血液検査というと、赤血球や白血球、血小板の値が低い、高いなどといったCBCと呼ばれる検査や、
肝臓や腎臓の値が高いなどといった血液化学検査と呼ばれる検査などを思い浮かべる方が多いと思います。
「値」として出るものは、多くの場合基準値もあり、理解しやすいですが、
それ以外にも、血液の細胞を直接みて、色々考えることができます。
血液の中を直接診る方法として、スライドガラスを使って血液塗抹を作成し、それを染色して顕微鏡でみる方法が一般的です。
このような感じで、血液の細胞を顕微鏡でみます。
このような感じで、血液の細胞を顕微鏡でみます。
赤血球や血小板、白血球(好中球)などが観察できます。
近年では遺伝子検査や分子マーカーなどの分野がどんどん進歩し、血液形態学は少し肩身が狭くなったように感じますが、
血液の形態をみることで身体の様々な変化を知ることができる、とても大切な検査だと思います。
最近、興味深いことを勉強しました。
いつも見ているこの血液塗抹は血液を乾かして、染色して作成します。
当然、この細胞は動くことはない、言わば「死細胞」です。
血液を生の状態で評価する方法として、位相差顕微鏡を用いる方法があります。
位相差顕微鏡を用いて、血球をみると次の動画のようなものがみえます。
分かりますか??画面中央にある細胞が好中球です。
よく動いているのが分かります。気持ちが悪く感じる方もいるかもしれませんが、
僕はこれを見た時、衝撃をおぼえました。まさに「生きている」ことを目の当たりにしたからです!
好中球が遊走するとはこのような感じなのか?
細胞内の核はこんなにも柔らかく、ダイナミックに動き、ミトコンドリアをみることができる。
この動画では確認しづらいですが、もっとじっと見ていると、核の中の核小体、クロマチンの状態などを
観察することができます。
血液同様に、骨髄液でも観察することができます。
まだまだ僕にはどれがどの細胞なのかを判断できませんし、この結果を治療に結びつけることができません。
そのような獣医学の本はないですし、医学の本もとても少ないです。
ここから少しでも、何か発見できたらと思うと、ワクワクします!
ややマニアックな話でした。
次回はまた論文の話にしようかと思います。

今年も生い茂っています。ミョウガがたくさんできますように。
診療時間の変更などがメッセージとして届きます。
また、当院を受診されている飼い主様に限り、フードの注文などもLINEからできるようになります。
是非ご登録ください。










